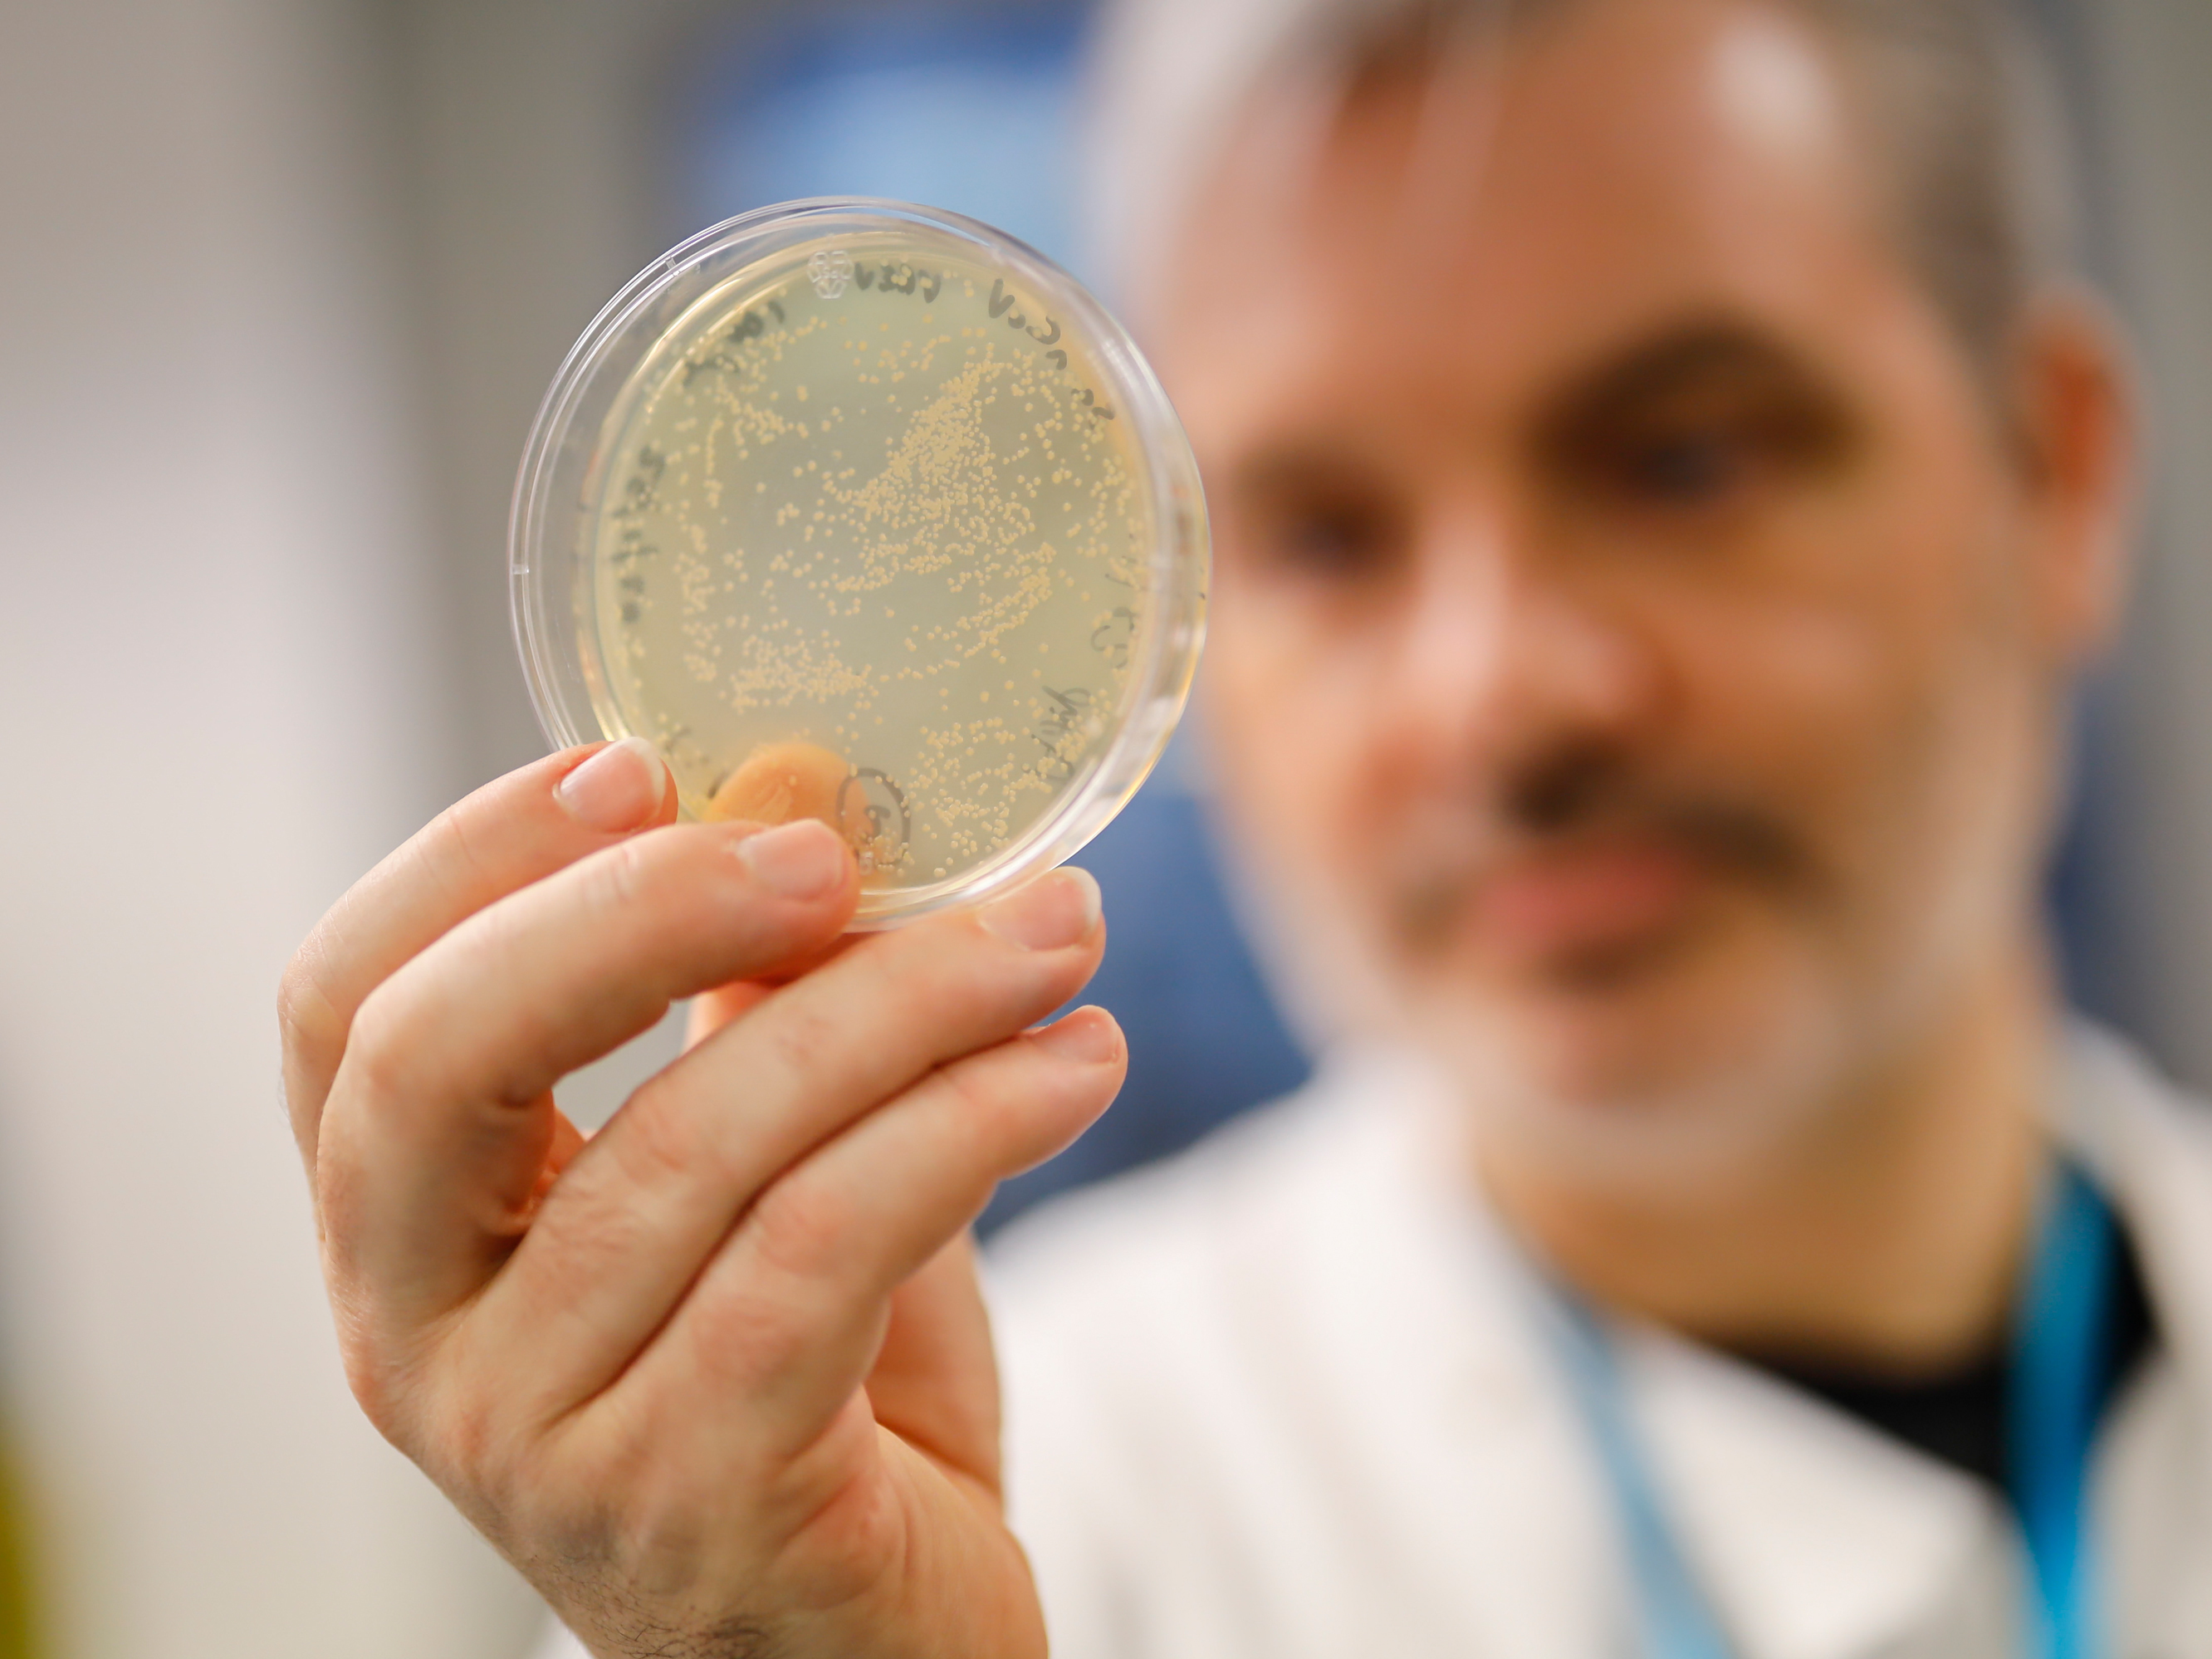
caption: Paul McKay, a molecular immunologist at the Imperial College School of Medicine in London, checks a dish of bacteria containing genetic material from the new coronavirus. He and his team are testing a candidate vaccine.

Joe Palca
Stories
-
More Questions About The Search For Coronavirus Medical Treatments
An NPR science correspondent answers listener questions about the search for medical treatments to fight the coronavirus.
-
Questions About Hydroxychloroquine, Touted As A COVID-19 Treatment
Dr. Jinoos Yazdanya, a rheumatologist from the University of California, San Francisco, and NPR science correspondent Joe Palca answer questions about the drug hydroxychloroquine.
-

Could Society Move Toward Normalcy Before A Coronavirus Vaccine Is Ready?
The best protection against the coronavirus would be a vaccine. But that's probably at least a year away, even if crash development programs succeed. What can be done in the meantime?
-

FDA Supports Effort To Develop COVID Treatment From Plasma Of Recovered Patients
The Food and Drug Administration announced Friday that it will take charge of a program that includes the Mayo Clinic and the American Red Cross with funds from the federal government.
-

Clinical Trials Set To Determine If Anti-Malaria Drug Effective Against COVID-19
At least one team of scientists hopes to determine if hydroxychloroquine — touted by President Trump as a possible treatment for COVID-19 — could actually work to prevent the disease.
-

U.S. Flu Season Beginning To Ease, Modelers Say
Though COVID-19 has captured the headlines, influenza places a huge burden on the health care system. This year's flu shot provides good protection, the CDC says, so do get one if you haven't already.
-
In The Fight Against COVID-19, Labs Look To Create Coronavirus Antibodies
An approach to treating new diseases that worked for the Ebola and Zika viruses is being tested for the new coronavirus. It involves using antibodies to the disease as a drug.
-
Timetable For A Vaccine Against The New Coronavirus? Maybe This Fall
Recent advances in biotech make scientists optimistic that they might have a vaccine that has passed basic tests of human safety and efficacy ready to go to clinics as soon as this fall.
-
Electrical Field May Speed Wound Healing By Encouraging Cell Regeneration
A scientist in Wisconsin has invented a bandage that uses an electrical field to speed up the time needed for a wound to heal. It could one day lead to treatments for baldness and obesity.
-
What's Ahead For The U.S. Space Program
The coming year is supposed to bring some important launches into space. It's possible private companies will successfully launch humans into space, and missions to Mars and the sun are planned.